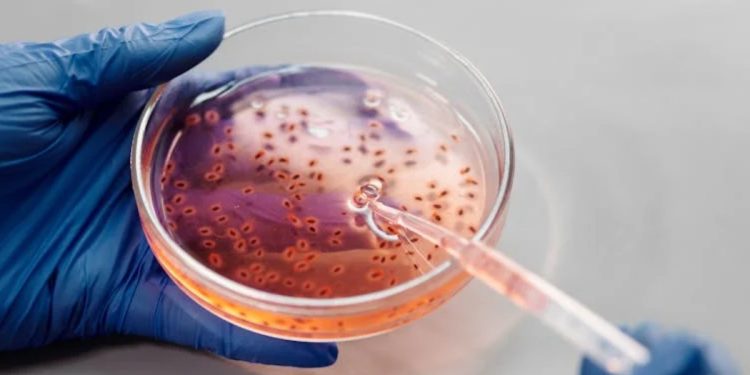
Microorganismi dentro un contenitore (Fonte: Pexels)

Rappuoli, i batteri migliorano la vita
Da sempre abbiamo visto in batteri e virus qualcosa di negativo e dannoso ma il microbiologo Rino Rappuoli propone una chiave di lettura diversa a riguardo. Spiega infatti perchè non occorre demonizzare questi microorganismi e la risposta sta nel fatto che da miliardi di anni provvedono alla loro vita, proprio come fa l’essere umano, cercando cibo, riciclando gli scarti e provvedere in generale al loro sostentamento. Il microbiologo sottolinea che da questi organismi ci arrivano fertilizzanti, biocarburanti e anche farmaci che sono tutti prodotti utili al genere umano per diversi usi e diverse circostanze.
I batteri vengono anche usati, come sostiene Rino Rappuoli, per pulire le acque e a tale proposito afferma che nel 2025 in Francia nascerà il primo stabilimento di “batteri mangiaplastica” capace di smaltire 50 mila tonnellate di pet all’anno. “Tutti gli obiettivi per lo sviluppo sostenibile fissati dalle Nazioni Unite, dalla salute alla fame al cambiamento climatico, possono essere raggiunti più facilmente con l’aiuto dei batteri” queste sono le parole del microbiologo riportate da la Repubblica in merito all’utilità che i microorganismi possono avere nella vita di tutti i giorni.
Rappuoli, dai vaccini ai batteri
Durante l’intervista rilasciata a la Repubblica, il microbiologo Rino Rappuoli risponde ad alcune domande tra cui quella riguardante il perchè, essendosi sempre occupato di creare vaccini abbia deciso di cambiare campo. Ha risposto sostenendo che, di solito, quando ci si occupa di batteri si pensa solamente a quelli che ci causano del male o ci fanno ammalare ma bisogna cambiare prospettiva e pensare che ci sono trilioni di specie che 3,8 miliardi di anni fa hanno generato vita sulla terra. In merito a questo ha anche affermato a la Repubblica che i batteri sono fondamentali per la vita di ogni singolo individuo nonché per la salute del pianeta. “Abbiamo batteri che migliorano la salute.
Vivendo nel nostro intestino regolano il funzionamento del sistema immunitario”. Continuando l’intervista il microbiologo ha parlato anche dell’importanza di una buona alimentazione al fine di mantenere una buona percentuale di microorganismi, “L’alimentazione di oggi e gli antibiotici tendono a ridurre il numero di specie di questo microbioma, facendo aumentare allergie, malattie autoimmuni e – si è scoperto di recente – rendendo meno efficaci le terapie contro i tumori. Con i nutrimenti giusti però possiamo ripristinare la loro ricchezza”, sono state queste infatti le sue parole in merito riportate da la Repubblica